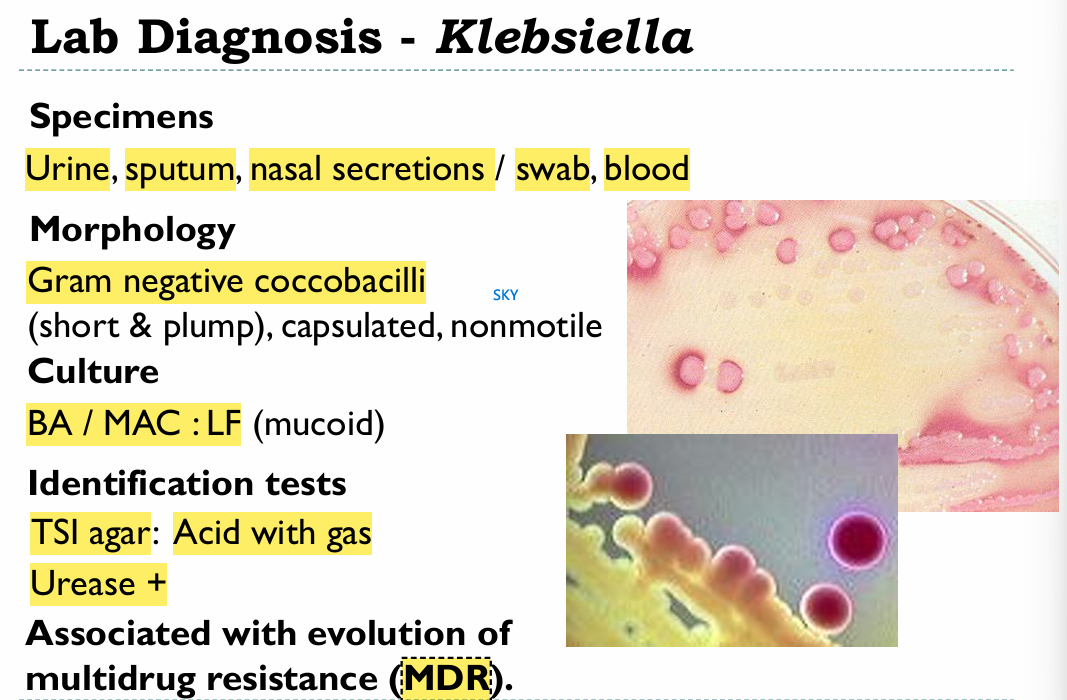
knowt flashcard image

1/89
Looks like no tags are added yet.
Name | Mastery | Learn | Test | Matching | Spaced |
|---|
No study sessions yet.
What are the general characteristics of enterobacterales (9) (mention exceptions)
Gram-negative rods
Aerobic/ FA
Non-encapsulated EXCEPT Klebsiella
Non-spore formers
Motile with peritrichous flagella EXCEPT: Shigella and klebsiella - Non-motile, and Yersinia enterocolitica - motile at 22C but not at 37C (SKY)
Grow on MacConkey (Bile salt + Crystal violet →Selective against G+ | Lactose + phenol red → Differentiate based on lactose fermentation)
Grow between 10-40 (optimal 37)
Oxidase -, Catalase + (S. dysenteriae is Cat -), Nitratase + (nitrate reductase), Glc + (with exceptions
High rates of conjugation and transduction

Differentiate between Enterobacterales based on their biochemical characteristics
Very important to separate enterobacterales into lactose fermenters and non-fermenter
Note: In the image, disregard Oxidase, they’re all Oxidase negative

What are the culture media used for enterics
MacConkey agar
EMB agar
Salmonella Shigella agar (SS)
Triple Sugar Iron agar (TSI)
How does Enterobacterales serotyping work?
Based on 3 antigens:
K - Capsular Ag (Majority don’t have it, and in the case of Salmonella, it’s called Vi)
O - Somatic Ag
H - Flagellar antigen
What are the main E.coli virulence factors
Structural virulence factors
LPS surface O Ag - Septic shock + Protects from phagocytosis and complement system
Envelope K Ag - Protects against phagocytosis → Can help it in causing pneumonia and neonatal meningitis
Fimbriae (P Pili) - Help the bacteria colonize (GI colonization > Diarrhea/ UT colonization → UTI)
Exotoxins (Cause of diarrhea)
Labile Toxin (Heat-labile) - LT
Stable Toxin (Heat-stable) - ST
Verocytotoxin or Shiga-like toxin - VT
Hemolysins (may be nephrotoxic)
Explain the mechanisms of LT and ST
LT → Adenylyl cyclase activation → cAMP → Secretion of Na+ and Cl- → Water follows
ST → Guanylyl cyclase activation → cGMP → Inhibition of ionic uptake in enterocytes → Osmotic loss of water from cells
What clinical presentations can E. coli be associated with
UTIs
Diarrhea
Septicemia → Septic shock
Pyogenic infections
Wound infections (Especially after lower intestinal tract surgery)
Biliary tract infection
Neonatal meningitis
Peritonitis
What E. coli serotypes are responsible for UTIs
The same ones found in feces
How does E. coli cause UTIs?
2 routes:
→ Ascending = via urethra
→ Descending = Hematogenously

How do the kidneys and bladder get infected generally
Kidneys may become infected by urine backflow, while the bladder usually gets infected by incomplete urine emptying
What are the physiological cause of UTIs in women
The rectum and vagina are in close proximity to the urethra, which is significantly shorter than the urethra in males → Easy ascend
What are the physiological causes of UTIs in men
The penis can easily come in contact with bacteria that can travel upwards the urethra (However urethra is quite long, so much less likely to get cystitis).
Prostate enlargement in males may block urine flow and cause infections
What does the presence of nitrite in urine indicate
It indicates the presence of enterobacterales, since they are nitrate reductase +
UTI stuff

What kind of urine specimens are used for UTI assessment
Mid-stream urine
Catheter specimen urine
Suprapubic aspiration
*Note: In case of urine retention, might need to directly remove urine from bladder

Review this slide later
Explain the Kuss semi-quantitative method
Diagnoses UTIs depending on bacterial count:
<10000/mL = Contaminant unless there are symptoms
10000 to 100000 = Inconclusive results → Repeat test. If symptoms are present → Bacteriuria
>100000/mL = Significant bacteriuria
Exceptions: If patient is taking antibiotics or diuretics, or if the pathogen is S. Aureus, then even small numbers can be significant
What mediums are used to culture E. coli
Blood agar, MacConkey
Biochemical identification of E. Coli
If we have an organism that’s G -, Indole +, Rod → 90% E. coli
What clinical conditions is EPEC associated with
Infantile diarrhea
institutional outbreaks.
Describe pathogenesis in EPEC
EPEC adhere via fimbria and disrupt the brush border microvilli → Diarrhea (Noninvasive; Nontoxigenic)
What are the symptoms that we see in EPEC
Fever, diarrhea, vomiting, nausea, non-bloody stools BUT with mucus
EPEC diagnosis
Culture on BA/MA
EPEC O antigen serotyping
What does ETEC cause
Traveler’s diarrhea
ETEC Pathogenesis
Production of plasmid-encoded toxins (LT/ST) - (Noninvasive, toxigenic)
Clinical features of ETEC
Watery diarrhea, vomiting, abdominal pain
ETEC diagnosis
Demonstration of the presence of enterotoxin
DNA probes for LT/ST
EIEC Pathogenesis
EIEC invade the epithelial cells by endocytosis and can spread laterally to adjacent cells → Tissue destruction and necrosis → Dysentery
Lab diagnosis of EIEC
Virulence marker antigen ELISA (VMA ELISA)
DNA probes
EHEC main virulence factor
What’s the most common EHEC serotype
EHEC produces verocytotoxin - VT, a Shiga-like toxin (SLT) (aka Verocytotoxigenic E. coli VTEC)
O157:H7
What the mechanism of action for Verocytotoxin?
It targets vascular endothelial cells and mucoal epithelial cells and inhibits protein synthesis → Cytotoxicity
Explain EHEC detailed pathogenesis
Here’s what maybe happens
EHEC attaches to gut mucosa epithelium
EHEC starts producing VT
VT moves to the lamina propria, either by Leakage or transcytosis → May then enter the circulation (HUS cause)
VT can only enter and disrupt protein synthesis in cells that express Gb3, this includes endothelial cells of the lamina propria, and those of kidney Glomeruli
In the gut, necrosis of endothelial cells due to VT leads to ischemia → Indirect damage to enterocytes of the mucosa + leakage of blood from the lamina propria into the intestinal lumen (Hemorrhagic colitis)
Damage to endothelial cells of kidney glomeruli + Widespread damage to RBCs leads to the formation of microthrombi that can block the already damaged kidneys → Triad of Acute Renal failure, hemolytic anemia, and thrombocytopenia
What are EHEC outbreaks associated with
Fast food - Hamburgers
Undercooked meat
Raw leafy vegetables (Especially vegetables grown by natural fertilizers since EHEC is a normal part of cattle microbiota)
How can we diagnose EHEC
By demonstration of bacilli or VT in stools
or
DNA probes for VT
or
Culture: On Sorbitol MacConkey agar or blood agar
→ Unlike other E. coli, they cannot ferment sorbitol → Colorles/pale colonies
→ EHEC is Hemolytic on blood
E. Coli treatment
No.1 = Fluid replacement
No.2 if severe and systemic (e.g. HUS) = Antibiotics
What is the reservoir for salmonella species
Intestinal tracts of warm and cold-blooded animals
What are the salmonella species
2 Species
Salmonella enterica (Many subspecies + over 2500 serotypes), Serotypes include:
Typhoidal:
→ Typhi
→ Paratyphi
Non-Typhoidal:
→ Enteritidis
→ Typhimirium
→ Paratyphi
→ Choleraesuis
Salmonella bangori
What are the 2 clinical manifestations that can be produced by salmonella species depending on serotype?
Explain the detailed pathogenesis in both cases
In typhoidal serotypes, we get Enteric fever (typhoid fever), and in non-typhoid, and:
Pathogenesis: Salmonella mainly invades the gut through M-cell mediated transcytosis, after which it is phagocytosed by the macrophages of the lamina propria.
In typhoid serotypes: Phagocytosis is ineffective due to the Vi capsules of salmonella that prevent the fusion of lysosomes with phagosomes → Macrophages act as trojan horses and transport the bacteria systemically
In non-typhoidal serotypes: Phagocytosis is eventually complete; however, inflammation is very severe at the level of the intestines due to the lack of immune evasion → Enteritis
However, they can still cause systemic diseases in old, young, or IC patients. AND, in sickle cell anemia, they’re also associated with osteomyelitis (Mostly non-typhoids)
How does salmonella keep being shed in feces for months
It uses cholesterol gallstones, which provide a solid surface to establish a biofilm → Chronic shedding
And if immunity wanes → Re-infection
Do typhoid and non-typhoid salmonellas have the same reservoirs
No,
Typhoid → Only humans
Non-typhoid → Humans and animals
Describe the documented symptoms of Typhoid fever
Enteritis-like: Headache, malaise, anorexia, abdominal pain/discomfort coated tongue
ONE LOOSE STOOL FOLLOWED BY CONSTIPATION
*Note: If someone is at the stage of constipation, we have to take a blood sample to test, not a stool sample
Rose spots - Truncal maculopapular rash
Flu-like: Prolonged fever, chills, bradycardia, dry cough, epistaxis (nose beeds)
Bacteremia: Soft palpable spleen, hepatomegaly
Chronic infection: Low WBC count, but Monocytosis (seen in chronic)
Compare enteritis and Typhoid fever
Slide 43

What are the methods for Salmonella isolation (Samples used)
Blood culture (Gold standard - 80-100% accuracy in detecting bacteremia)
Stool culture
Bone marrow (Rare)
Describe the non-cultural diagnostic techniques for salmonella
Widal test: Detection of antibodies (Inclonclusive cuz depends on stage of the disease)
Detection of antigens in blood and urine
When should we do blood culture vs stool culture
Should do blood cultures in the early stages of the disease, because bacteremia occurs in the early stages.
Stool culture is best in the later stages of the disease (Chronic shedding thing). 80% sensitivity in 3rd week patients

For how long do nontyphoidal strains keep being shed in stools?
for 4-5 weeks and rarely, for over a year - Slow clearance
Salmonella culture
MCA/DCA → Pale (cuz NLF)
Hektoen enteric agar (HEA) → Positive H2S → Cat eye colonies
Note: S. typhi i a weak H2S producer
SS → Black colonies with silver/metallic sheen
EMB → Colorless/Light purple (NLF)
TSI → + H2S and Gas

Describe Salmonella’ environmental resilience
Survives on:
55º C – 1 h
60º C – 15 min
Boiling, Chlorination, Pasteurization destroy the Bacilli.
Salmonella Gastroenteritis treatment
Replace lost fluids orally and IV
Antibiotics actually worsen things in uncomplicated cases:
→ Don’t shorten illness
→ Prolong carrier state due to dysbiosis
→ Increase risk of relapse
* Give ABios if IC or severe disease or infants
Typhoid fever treatment for resistant and non-resistant strains
Non-resistant:
Fluoroquinolones (Ciprofloxacin) PO or IV
Ceftriaxone or Cefepime
Resistant:
Ceftriaxone IV
Azithromycin PO
High-dose Ciprofloxacin (Only if isolates were tested and found to be less susceptible)
Salmonella vaccine
*Both for typhoid, none for enteritis
Oral vaccine: Live-attenuated vaccine
IM Vaccine: Vi capsular polysaccharide
What are the shigella species
Shigella dysenteriae (Group A) - The only one which produces Stx
Shigella flexneri (Group B) - Developing countries
Shigella boydii (Group C)
Shigella sonnei (Group D) - Industrial world
What’s the major cause of bacillary dysentry
Shigellosis
What are the reservoirs for shigellas
Humans only
How high is the infectious dose for shigella
It’s quite low (102-104 CFU), cuz its acid-stable
Shigella incubation period
1-3 Days
What is Shigella’s epidemiological significance
Common in Pediatric age group (1-10 yrs)
Leading cause of infant diarrhea & mortality in developing countries
Outbreaks in daycare centers, nurseries, institutions
Explain shigella pathogenesis and symptoms
Shigella enters through M cells → Phagocytosis by waiting macrophages → Shigella triggers macrophage pyroptosis which causes massive neutrophil recruitment which disrupt tight junctions and increase permeability, which appears as Watery diarrhea (May contain some blood & mucus)→ Shigella is released and enters enterocytes of the mucosa through their basolateral sides → Now shigella can manipulate actin filaments to spread from cell to cell laterally → This causes epithelial cell death + mucosal ulceration
Add intense inflammation + microvascular damage → blood + mucus + pus in stool (Dysentry) + Fever (If S. dysentariae cuz Stx is also neurotoxic)
What are the common shigella complications
HUS/ Reiter’s syndrome (arthritis)
What kind of specimens do we use for shigella
Stools or rectal swab from ulcer
Describe fecal microscopy in shigella vs amoebic dysentries
Shigella: RBC + lots of pus cells
Amoeba: RBC but few pus cell
Shigella treatment
Adults: Rehydration + Norfloxacin or Ciprofloxacin
Children: Rehydration + TMP-SMX or Ampicillin
Shigella precention

What is the pathogenesis for Y. pestis
S66

What is the pathogenesis for Y. enterolitica and Y. pseudotuberculosis

What are the clinical manifestations of Y. pestis

How can Y. enterolitica be acquired
Contaminated milk/pork/ contaminated market meat (by feces) and vacuum-packed beef
Y. enterolitica clinical manifestations
Gastroenteritis + fever
OR
Bloody diarrhea, pseudoappendicitis, reactive arthritis (adults)
Y. enterolitica lab stuff and treatment

List the klebsiella species
K. pneumoniae, K. oxytoca, K. ozaenae, K. rhinoscleromatis
What differentiates Klebsiella pneumoniae
It has a polysaccharide capsule that protects it against phagocytosis/antbiotics.
In the lab: The capsule causes the growth of moist-mucoid colonies with a yeasty odor
What are the clinical manifestations of Klebsiella pneumoniae
Pulmonary infection/ Aspiration pneumonia:
→ Dark red “currant jelly” sputum + Abcesses in lungs and liver
Meningitis & Enteritis in infants
UTIs
Septicemia
Nosocomial infections (OXA48)
Pneumonia and drug abuse and alcohol
Drug abuse - think S.aureus
Alcoholism - Think klebsiella
Klebsiella lab stuff
Where are enterobacter, Serratia, and Citrobacter commonly found
Moist environments and hospitals
Name the enterobacters
Isolation specimen
Characteristic
→ E. aerogenes / E. cloacae
→ Isolated from wounds, urine, blood, CSF
→ Colonies resemble lebsiella, also MOTILE
Name the serratias
Only S. marcescens
What is the clinical significance of Serratia
Responsible for nosocomial infections of UT/RT.
Associated with nurseries and cardiac sergeries, and burn units
Serratia biochemical characteristics
Produce characteristic pink pigment, especially when cultures are left at room temperature
Slow LF
Citrobacter species
Citrobacter freundii
What clinical manifestations is citrobaccter associated with
Nosocomial infections and UTIs/ Pneumonia
Citrobacter biochem
Ferments lactose
Hydrolyzes urea slowly
Citrate +
What are the characteristics of Morganella, Proteus, and Providencia (MPP)
All part of our normal flora, and all opportunistic pathogens
Phenylalanine demaminase (PDA) +
Lactose -
Why is proteus called proteus
Cuz it’s pleomorphic
Proteus species
P. mirabilis and P. vulgaris
Where can proteus be isolated
Urine - Associated with urinary catherization, wounds, ear, blood infections (bacteraemia)
*Note: In case of catheterization, urine pH can tell us about proteus infection
Proteus biochemistry
Urease +
PDA +
Gelatinase +
H2S+ on TSI (Look scheme in general characteristics)
Morganella morganii everything
Causes UTIs
Urease +
PDA +
H2S -
Providencia species and their clinical significance
Providencia rettgeri and stuartii
Cause UTIs and nosocomial outbreaks
H2S negative on TSI
What are ESBLs
Plasmid-encoded Extended-spectrum Beta-lactamases
→ Destroy Penicillins, Cephaloporins, Azteronam. ALSO, non Beta-lactamase antbiotics (FQs/AGs/TMP)
Produced by some E. coli and Klebsiella strains
Counter: Carbapenems (However, there are Carbapenemase producers now)